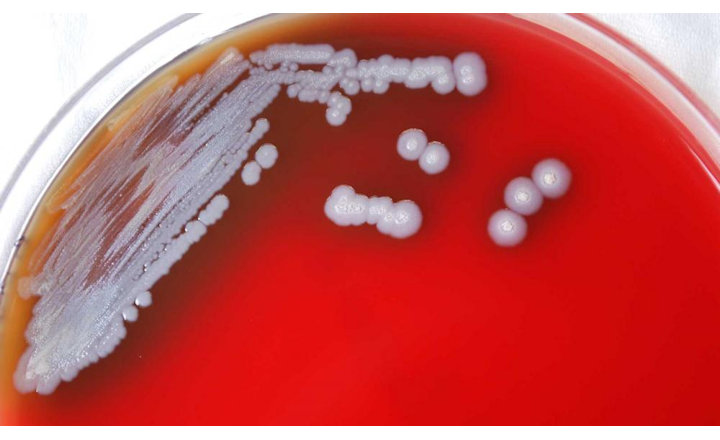

O nouă bacterie care provoacă o boală rară și gravă a fost descoperită în SUA
Bacteria care cauzează o boală rară și gravă numită melioidoză a fost detectată în probe de apă și sol din Mississippi.
„Încă nu sunt informații certe despre perioada în care bacteria a fost în mediu înainte de 2020 sau cât de răspândită este bacteria în Statele Unite. Testele sugerează că aceste condiții de mediu din statele de pe coasta Golfului sunt favorabile dezvoltării Burkholderia pseudomalleiȚ, a comunicat CDC.
Experții CDC au cerut medicilor din întreaga țară să ia în considerare melioidoza ca posibil diagnostic atunci când oamenii au simptome, „deoarece melioidoza este acum considerată a fi endemică la nivel local în zonele din regiunea Coastei Golfului din Mississippi.